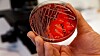
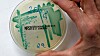

antibiotika

Svein-Erik Hole
Ansvarlig redaktør for ABC Nyheter
Her finner du mer innhold om samme emne– og én artikkel jeg mener fortjener litt ekstra oppmerksomhet. God lesing!
Annonse
Annonse
Annonse